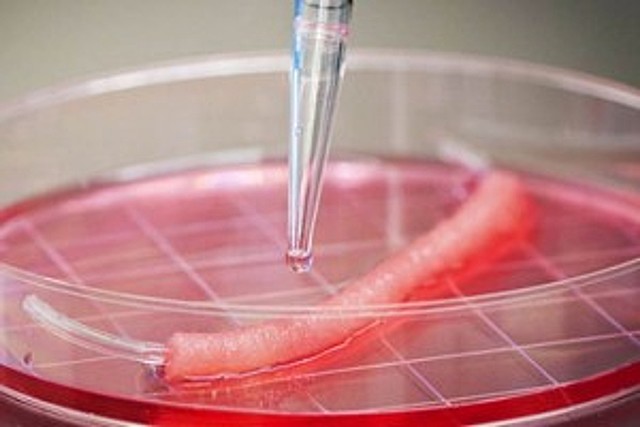
Animal

-
Se establecen técnicas de perduración, observación y visión de realizar los cultivos de células de manera aislada
-
Bichat investiga y nombra los tejidos del cuerpo y enfatiza el estudio de los diferentes tejidos que componen los órganos.
-
Ludwig mantiene vivos los órganos animales fuera del cuerpo bombeando sangre a través de ellos.
-
Wilhem Roux mantuvo células de embrión de pollo en solución salina durante unos días.
-
Schleiden y Schwan describen su teoría celular: la célula puede sobrevivir solamente si las condiciones a las que se enfrenta son óptimas.
-
Haberlandt lleva a cabo el primer cultivo in vitro de tejidos vegetales empleando la totipotencialidad celular.
-
Harrison fue el primer científico que empleó técnicas in vitro para el estudio de fenómenos in vivo, realizando cultivos de médula espinal embrionaria de anfibios.
-
Burrowsel logra establecer un medio de cultivo adecuado para el cultivo de células animales utilizando plasma de pollo.
-
Se utilizó por primera vez extractos de tripsina (gracias a Roux y Jones).Se crea 1er cultivo celular conocido y funcional. Aún se presentan problemas de conservación debido a la contaminación del cultivo.
-
Carrel demostró la posibilidad de mantener en cultivo células extraídas de un animal,, durante un periodo de tiempo superior al de la vida de éste, utilizando el llamado frasco de Carrel.
-
David Thompson comienza a experimentar con el cultivo de órganos, explantando los dedos de los pies, los gérmenes de las plumas, el lente óptico y la yema de la cola de los polluelos embrionarios.
-
Ebeling logra cultivar células epiteliales.
-
El primer avance en la proliferación de tejidos vegetales en condiciones in vitro fue fruto del trabajo de W. J. Robbins y Kotte.
-
Warburg desarrolla un método para estudiar la respiración en láminas delgadas de tejido.
-
Parker y Nye inoculan fragmentos de testículos de conejo con virus vaccinia y los cultivan en plasma.
-
Fell estudia el desarrollo de huesos y articulaciones in vitro utilizando fragmentos de órganos en desarrollo de embriones de pollo.
-
White (EUA) pudo hacer crecer indefinidamente el tejido de raíces de zanahoria y tabaco evidenciando el desarrollo progresivo de células (callo=callus).
-
Beveridge y Burnet describen el cultivo de virus y rickettsias en el embrión de pollo.
-
La Conferencia de Cultivo de Tejidos celebrada en Hershey, Pensilvania inicia la fundación de la Asociación Estadounidense de Cultivo de Tejidos.
-
La Rue cultivó gametofitos masculinos. El polen se desarrolla en un cultivo óptimo. Ball regeneración de órganos por medio de callos en cultivos in vitro.
-
Gry y col, establecen la primera línea celular continua HeLa utilizando plasma de pollo, extracto de embrión bovino y suero de cordón umbilical humano.
-
Rita Levi-montalcini y col, mostraron que el factor de crecimiento nervioso estimula el crecimiento de los axones en tejidos en cultivo “Premio Nóbel para Levi-Montalcini en 1986”.
-
Rocker, Hidelbrand y Muir por medio de técnicas in vitro establecieron los primeros cultivos en suspensión utilizando cultivos nodriza de células aisladas en la regeneración de plantas. F. Skoog identificó la kinetina la cual es una sustancia reguladora de la división celular.
-
Harriss induce la hibridación de células a gran escala.
-
Morel pudo probar la propagación vegetativa en orquídeas en un cultivo de meristemos.
-
Hayflick y Moorhead, usaron por primera vez antibióticos en un medio de cultivo para prevenir la contaminación de los cultivos de fibroblastos.
-
Murashige y Skoog estudiaron los requerimientos minerales de cultivos celulares de tabaco, obteniendo una formulación que actualmente es la más utilizada globalmente en el cultivo de tejidos vegetales.
-
Ham introduce el primer medio definido libre de suero capaz de mantener algunas células de mamífero en cultivo indefinidamente.
-
Guha y Maheshwari, obtienen las primeras plantas haploides al cultivar antenas de “datura inoxia”. Factor para su obtención: genotipo de la planta.
-
Augusti-Tocco y Sato establecen la primera línea celular estable de neuroblastoma. Se empiezan a establecer las primeras líneas celulares diferenciadas.
-
Withers y Kartha, cultivo continuo en quimiostato.
-
Zenk, hibridación somática. Obtención de los primeros tomates híbridos (pomato)
-
Kohler y Milstein establecen la primera línea celular híbrida productora de anticuerpos monoclonales. Les valió el Premio Nóbel.
-
Sato y Col, mostraron las diferentes líneas celulares que requieren mezclas distintas de hormonas y factores de crecimiento para crecer en medios libres de suero.
-
Dell-chilton et al, producción en dos etapas.
-
Krens et al, inmovilización celular.
-
Horsh et al, cultivo de raíces transformadas (hairy roots)
-
Petrochemical, tabaco transgénico.
-
Redenbaugh, semillas sintéticas.
-
Tabata y Fujita, cultivo de células a gran escala.
-
Eilert y Constabel, elicitación de alkaloides.
-
Giles, producción de sanguinaria.
-
Empezaron a producirse medicamentos a escala industrial en biorreactores. Se desarrolla la biotecnología.
-
Genetech, tomate (jitomate) transgénico.
-
Se produce cartílago mediante ingeniería de tejidos.
-
Experimentación del auge de ingeniería de tejidos.
-
Takahashi, se reprograman células adultas humanas para convertirlas en células pluripotenciales inducidas.